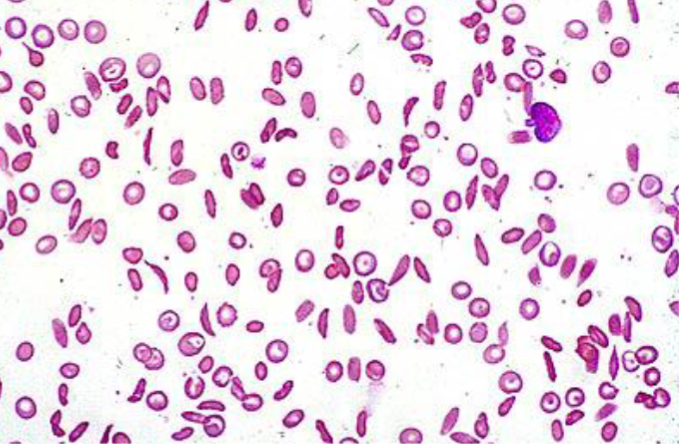

Patient Case: Acute Lymphoblastic Leukemia
- Patient presented with fever, pallor, petechiae. This is his peripheral smear
- What is the diagnosis?
- Acute Lymphoblastic Leukemia
- Other Signs you can find in the patient?
- Anemia signs → dizziness, pallor
- Thrombocytopenia → Petechiae, purpura
- Recurrent infections.
- Bone Pain
- Weight loss
- Prognosis of the disease?
- Good prognosis if treated, children are cured in 90%
- Males are treated for 3 years, females are treated for 2 years
Patient Case: Kawasaki Disease
- Picture: show strawberry tongue
- What is the most likely diagnosis? Kawasaki Disease
- What is the serious complication that might develop? Coronary Artery Aneurysm (not sure)
Z A 3 year old boy is brought to your general pediatric clinic with left knee pain. Upon further history taking, you elicit that the pain has lasted for 5 days. Today, he is unable to bear weight and the left knee is swollen. His mother has given him acetaminophen periodically the past few days; however it has not provided him with relief. There is no history of injury or trauma. He has a decreased appetite, periodic abdominal pain, but has not had vomiting or diarrhea. The family originally from Alhasa region. Mom says that the knee is warm to touch, but there is no redness.
Exam: VS T37.7, P 100, R 30, BP 98/52. he is nontoxic appearing. he has anicteric sclera, clear conjunctiva, a non-injected pharynx and normal TMs. No cough is heard during the exam. His lungs are clear to auscultation. His heart is regular without murmurs.
-
a- Write 3 relevant questions, to ask the mother?
- -family history oF SCD -history of foot and hand swelling
- -fever - irretabilty -history of recurrent jaundice or painful crises
- -previous blood transfustion -vacction -trauma
-
b- What specific signs you should look for during examination of this infant?
- Splenomegaly -hepatomegaly -pallor
- skin rash -dehydration
-
c- What are the important investigations?
- -cbc -blood culture -HB electrophoresis. -knee x-ray
-
d- What is the most likely diagnosis and give two differential diagnosis?
- -SCD with painful crisis or arthritis
- Septic arthritis -juvenile rheumatoid arthritis -hemophilia with haemarthrosis
-
e- Outline the management plan?
- IV fluid Pain killer (ibuprofen) Antibiotic consider blood transfusion genetic counseling avoid precipitating factor like dehydration, cold & hot weather
- folic acid omega3 hydroxyurea bone marrow transplant
Patient Case: Henoch-Schönlein Purpura (HSP)
History taking of a child with rash, abdominal pain, joint pain (HSP)

- 28 month girl come to dr. complain of bowing and failure to thrive shh took breast feeding for 9 month then start feeding
- Write two relevant question?
- What finding you will look to on examination?
- Write important investigation?
- Differential diagnosis?
- Treatment ?? and what advice the mother on future ?
Case Study: 9-Year-Old Girl with Joint Pain
History
9 years old girl presented with : Multiple joints pain & swelling+ Limitation of movement Decrease activity, fatigue Morning stiffness > 1/2 hr. Low grade fever on/off No history of the following:
- skin rash
- oral ulcer
- hair loss
- trauma
- Recurrent Infections
- urinary symptoms
- abdominal pain
- Past medical & surgical history:
- Not known to have any medical illness & no previous hospitalization.
- FAMILY & SOCIAL HISTORY:
- Living in Riyadh. father is government employer & mother is a house wife & the other 2 siblings healthy.
- No FHx of chronic disease in the family. musculoskeletal system:
- Upper limbs:
- bilateral swelling, effusion, tenderness & limitation of movement of small joints of hands, wrists, shoulder.
- Lower limbs:
- Bilateral knees & ankles: swelling, effusion, tenderness & limitation of movement.
- Temperomandibular tenderness and limitation of movement.
GAIT:
- unable to walk.
Physical Examination
- Looks Unwell, Pale & In Pain
- No Skin Rash
- Afebrile
- BP:101/76
- WT: 29.5 kg
- H.T: 148.5 cm
- No Lymphadenopathy
- E.N.T: Clear, No Oral Ulcers
Differential Diagnosis (DDX)
- ?
- DDX:
- R.F: -ve
- J.I.A poly arthritis R.F -VE
- Enthesitis - related arthritis
- Inflammatory bowel disease
- Systemic J.I.A
- Psoriatic J.I.A
- Polyarthritis related to infection
- Reactive arthritis
- Sarcoidosis
Investigations
- C.B.C:
- Wbc: 12.4
- Hb: 11.5
- Plt: 609
- E.S.R: 105 ( )
- C.R.P: 48 ( )
- R.F: +ve
- A.N.A: - ve
- A.S.O.Titer: normal
- brucella: normal
- Urine analysis: normal
- U/E: normal
- L.F.T: normal
- X-Ray:
Diagnosis
- JUVENILE RHEUMATOID ARTHRITIS
- ( POLY-ARTICULAR )
Management
- AIMS OF TREATMENT:
- Control pain
- Preserve range of movement
- Preserve muscle strength & function
- Manage systemic complication
- Facilitate normal nutrition growth, physical & psycological development.
- Treat other extra-articular complication:
- Uveitis, serositis, growth retardation & osteopenia
- Multidisciplinary team:
- Pediatric Rheumatologist.
- Nurse Clinician.
- Social Worker.
- Physical Therapist.
- Occupational Therapist.
- Psychologist.
Treatment
- I.V Methylprednisolone 30 mg/kg daily for 3 doses
- then Prednisone orally 15 mg BID then tapering doses
- Naproxen 250 mg tab P.O B.I.D
- Methotrexate 15 mg P.O Q week
- Folic acid 1 mg P.O O.D
- Zantac 150 mg P.O O.D
- Vitamin D 10 drops O.D
- Calcium 1 tab 500 mg P.O O.D
- Ophthalmology consultation ( normal ).
Follow Up
- patient showed good response to the treatment with improvement of the joint pain and she resumed her usual activities.
- JUVENILE RHEUMATOID ARTHRITIS
- ( POLY-ARTICULAR )
Patient Case: Rheumatic Fever
An 11-year-old male presents with fever up to 39 degrees (102 degrees F), joint pain and swelling, along with shortness of breath. The fever comes and goes at random times of the day. The symptoms have been present now for 4 days. Two days ago, his right knee was painful and swollen, but today it has improved. The joints involved today include the right ankle and left knee. They are quite tender, painful and also swollen. The shortness of breath occurs with walking, but he is now unable to walk because of the joint pain. He also has some shortness of breath with lying down flat when he is trying to sleep. Exam: VS T 38.2, P 160, RR 32, BP 100/60, oxygen saturation in room air. He is tired appearing with tachypnea and 94% tachycardia. HEENT: Enlarged, erythematosus tonsils with exudates. Lungs are clear but with tachypnea. His abdomen is soft with normoactive bowel sounds.
-
?Write two relevant questions, to ask the mother
- the boy have any recent sore throat or scarlet fever-1
- any complain from chest pain and shortness of breath-2
-
?b-What are the important investigations
- streptococcal antibody titer-1
- throat culture for group A betahemolytic streptococci-2
- ASO and antistreptokinase-3
- ESR and CRP-4
- chest x-ray-5
-
?c-What is the most likely diagnosis
- Rheumatic fever
-
?d-Write 2 differential diagnosis
- gonococcal arthritis-1
- juvenile idiopathic arthritis-2
- Lyme disease-3
-
? Outline the management plan
- treatment of group A strep infection-1
- general treatment of the acute episode: anti-inflammatory agent-2 for fever
- steroid -3
- cardiac management: bed rest-4
- prophylaxis penicillin-5
Patient Case: 5-year-old with Rash and Joint Pain
A 5-year-old boy brought by his mother who noticed a skin rash on his chest and he also c/o left knee joint pain. He was normal before that. On examination his vital signs are stable except the temperature it was high (38.5).
- What relevant questions you should ask the mother?
- Fever (duration, onset, course).
- Joint pain.
- Rash (all over the chest or in one part).
- FHx.
- What examination you will do?
- ?? joint examination
- What investigations you should order?
- X-ray of the joint
- Rheumatoid factor
- Blood culture
- ESR & CRP
- What’s your DDx?
- âś“ JRA.
- Rheumatic fever.
- HSP.
- Rheumatic fever.
- What’s your management?
- Antipyretic
- Painkillers. not Iboprofin to See if it was migratory
Case 6: 5-Year-Old Boy with Fatigue, Weakness, and Pallor
Scenario
A 5-year-old boy, presented with a history of fatigue and weakness. The family originally from the south province of kingdom and parents are first cousins. Clinical examination. The child’s weight was 13.9 kg (below 3rd percentile), height 109.5 cm (50th percentile), and head circumference was 54 cm (above 97th percentile). Markedly pale and also had mild clinical jaundice. Temp: 37.2, P 100, R 30, BP 98/52. He is nontoxic appearing. Lungs are clear to auscultation. Heart is regular with short systolic murmur grade 2/6 at ULSB. Signs of extra-medullary erythropoiesis were present, notably frontal bossing and maxillary hyperplasia. No significant lymphadenopathy.
1. Write 2 relevant questions, to ask the mother?
- Family history of the same condition, Any history of fractures
2. Mention 2 important specific signs you should look for during examination of this child?
- Hepatosplenomegaly, Depressed nasal bridge
3. Mention 2 important investigations?
- Hb electrophoresis, CBC, Skull X-ray
4. What is the most likely diagnosis, and give 2 differential diagnoses?
- Thalassemia, Sickle cell anemia and Hereditary spherocytosis
5. Mention 2 important points in the management plan?
- Blood transfusion “ Hb should be 9.5”, Iron chelating agents (Desferal)
Case 2: 2-Year-Old Boy with Purpuric Rash and Joint Swelling
Scenario
A 2-year-old boy develops a widespread purpuric rash, most prominent over the legs and buttocks. Although initially treated with 48 hours of intravenous antibiotics for meningococcal sepsis, no evidence for infection is subsequently found and this diagnosis is discounted. The child remains afebrile and well, but develops swelling of the knees and ankles and becomes reluctant to weight-bear.
a- Write two relevant questions, to ask the mother?
- Headache, anorexia before the onset of the rash
- Abdominal pain and vomiting.
- Subcutaneous edema
- Scrotal edema
- Bloody stools
- hematemesis
b- What specific signs you should look for during examination of this child?
- Skin findings
- Type of the rash: Erythematous macular / urticarial lesions/blanching papules /palpable purpura; hives, angioedema, target lesions.
- Is the rash is symmetrical
- What is the distribution: look in the ankles, lower legs, the back, buttocks, upper extremities, and upper thighs.
- Examine all joints for Arthralgia and swelling.
- priapism, penile edema, orchitis.
- CNS for bilateral subperiosteal orbital hematomas
c- What are the important investigations ?
- Antinuclear antibody (ANA) and rheumatoid factor (RF)
- Factors VIII and XIII
- Urinalysis
- Complete blood count (CBC)
- Platelet count
- Erythrocyte sedimentation rate (ESR)
- Stool guaiac test
- Blood urea nitrogen (BUN) and creatinine
- Amylase and lipase
- Electrolytes
- Plasma D-dimer
- Plasma thrombin-antithrombin (TAT) complex, prothrombin fragment (PF)-1, and PF-2
- Prothrombin time (PT) and activated partial thromboplastin time (aPTT)
- Serum IgA
- Antistreptolysin O (ASO)
- CH50
- C3 and C4
- Immunocomplexes of IgG and IgA
Imaging modalities that may be considered include the following:
- Ultrasonography (abdominal, scrotal/testicular)
- Radiography (chest radiography; plain radiography of the abdomen; contrast radiography of the small intestine; barium enema study)
- Magnetic resonance imaging (MRI; for assessing neurologic findings)
- Computed tomography (CT) of the head or abdomen
Other studies that may be warranted are as follows:
- Endoscopy
- Renal biopsy (particularly when nephrotic syndrome persists and when renal function deteriorates)
d- What is the most likely diagnosis and give two differential diagnosis?
- Idiopathic Thrombocytopenic Purpura
- IgA Nephropathy
- Inflammatory Bowel Disease
- Mononucleosis
- Orchitis
- Pancreatitis
- Chicken Pox or Varicella
- Gastroenteritis
- Gastrointestinal Bleeding
- Hand-Foot-and-Mouth Disease
- Intussusception
- Kawasaki Disease
- Meningitis and Encephalitis
- Septic Shock
- Systemic Lupus Erythematosus
- Acute Glomerulonephritis
- Acute Renal Failure.
e- Outline the management plan?
- Admission to the hospital and monitor for abdominal and renal complications,
- Adequate hydration;
- Immediate discontinuance of any exposure to antigenic stimulants (eg, drugs)
- Acetaminophen For minor complaints of arthritis, fever or malaise.
- Prednisone
- Plasmapheresis
- follow-up until abnormal urinary findings subside.
Case 7: Hemolytic Uremic Syndrome (HUS)
1-What are relevant questions you should ask the mother?
- 1- Is the patient having bloody diarrhoea?
- 2- Is the patient having oliguria or anuria?
- 3- Any signs of petechaie or purpure un explained bursies?
- 4- Any weakness and lethargy?
- 5- Any pervious soon GIT infection or food poisoning?
- 6- Family history of renal disease or bleeding disorder?
2-Which examination you will do?
- 1-Take vital signs
- 2- Abdomen
- 3-Neurologic
3-Mention 5 Investigation you will request for this patient?
- CBC to see anemia, thrombocytopenia, high reticulocyte.
- LFT > high AST, high indirect bilirubin. High amylase.
- RFT > high creatinine.
- Urinalysis >hematuria, protein, pyuria or casts.
- Stool culture >+ve E coli or shiga-toxin
4-Mention 3 differential diagnosis?
- 1-ITP
- 2- HUS
- 3- HSP
5-How to manage that patient?
- supportive, hydration, mange complication of renal failure, dialysis if needed, control HTN, RBCs transfusion as needed, No platelet transfusion no antibiotic or antidiarrhea
Case 9: 3-Year-Old Boy with Knee Pain
Scenario
A 3-year-old boy is brought to your general pediatric clinic with left knee pain. Upon further history taking, you elicit that the pain has lasted for 5 days. Today, he is unable to bear weight and the left knee is swollen. His mother has given him acetaminophen periodically the past few days; however it has not provided him with relief. There is no history of injury or trauma. He has a decreased appetite, periodic abdominal pain, but has not had vomiting or diarrhea. The family originally from Alhasa region. Mom says that the knee is warm to touch, but there is no redness. Exam: VS T37.7, P 100, R 30, BP 98/52. he is nontoxic appearing. he has anicteric sclera, clear conjunctiva, a non-injected pharynx and normal TMs. No cough is heard during the exam. His lungs are clear to auscultation. His heart is regular without murmurs.
a- Write 3 relevant questions, to ask the mother?
- -family history oF SCD -history of foot and hand swelling
- -fever - irretabilty -history of recurrent jaundice or painful crises
- -previous blood transfustion -vacction -trauma
b- What specific signs you should look for during examination of this infant?
- Splenomegaly -hepatomegaly -pallor
- skin rash -dehydration
c- What are the important investigations?
- -cbc -blood culture -HB electrophoresis. -knee x-ray
d- What is the most likely diagnosis and give two differential diagnosis?
- -SCD with painful crisis or arthritis
- Septic arthritis -juvenile rheumatoid arthritis -hemophilia with haemarthrosis
e- Outline the management plan?
- IV fluid Pain killer (ibuprofen) Antibiotic consider blood transfusion
genetic counseling avoid precipitating factor like dehydration, cold & hot weather
- folic acid omega3 hydroxyurea bone marrow transplant

Diagnosis:
- Iron Deficiency Anemia (IDA)
Peripheral Blood Film Findings:
- Hypochromic microcytic cells in severe iron deficiency anemia.
Question: Mention 2 signs from the picture?
- Microcytic and hypochromic red cells
- Poikilocyte
.

Legs with Petechiae:
- What is the only investigation that will help you? Platelet count
- What is the serious complication that might develop? Intracranial hemorrhage
- Answer Key (Diagnosis is ITP)
Petechial/Purpuric Rash:

- Palpable:
- Vasculitis
- Vascular damage to capillary-sized vessels
- Not Palpable:
- ITP (idiopathic thrombocytopenic purpura)
- Autoimmune in 60%
- 1½ new cases in children, 70% end in remission
Case Study: Urine Microscopy
4 year old boy dark urine and hypertension, urine microscope, anaalysis showed casts
Questions
-
Name the cast?
- RBC cast - * Post-Streptococcal Glomerulonephritis
-
What is the likely diagnosis?
- Acute glomerulonephritis
-
Other possible causes?
- Trauma, renal infarction, SLE
Case Study

- Patient presented with fever, pallor, petechiae. This is his peripheral smear. What is the diagnosis?
- Acute Lymphoblastic Leukemia
- Other Signs you can find in the patient?
- Anemia signs (dizziness, pallor)
- Thrombocytopenia (Petechiae, purpura)
- Recurrent infections.
- Bone Pain
- Weight loss
- Prognosis of the disease?
- Good prognosis if treated, children are cured in 90%
- Males are treated for 3 years, females are treated for 2 years
Case Study: Sickle Cell Disease (SCD)

Questions
- A-what is the diagnosis?
- SCD
- B-what is the diagnostic test?
- Hb electrophoresis
- C-give one complication to it?
- CHD, stroke …
- D-what the curative treatment for it?
- BMT bone marrow transplant
Henoch-Schonlein Purpura
What are the presenting symptoms of the 11-year-old female patient? Recent development of abdominal pain, joint pain, a new skin rash, and a positive Occult Blood Test.
What are the complications associated with Henoch-Schonlein Purpura? Abdominal pain, orchitis, adenitis, and vasculitis.

Mumps or Hodgkin Lymphoma
What are the clinical features? Rise of ear lobule and cheek swelling. What are the possible diagnoses? Mumps or Hodgkin lymphoma.

What is this rash?
- Erythema marginatum
- This criteria of? RF

Case
Sign ? Target sign Diagnosis? Thalassemia
Case
Diagnosis SCA